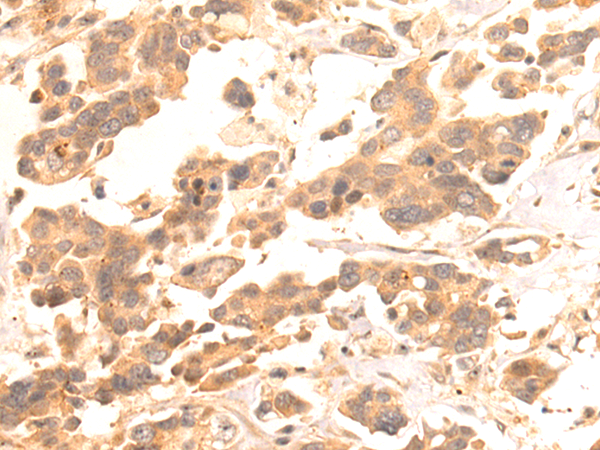
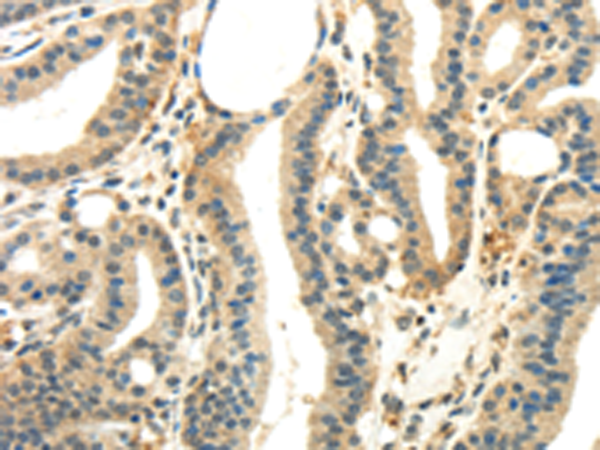

-
分类: 科研抗体货号: P12398别名: PS20应用: IHC反应种属: Human, Mouse
-
分类: 科研抗体货号: P12396别名: GLC1G; UTP21; TAWDRP; TA-WDRP应用: IHC反应种属: Human
-
分类: 科研抗体货号: P12413别名: API3; ILP1; MIHA; XLP2; BIRC4; IAP-3; hIAP3; hIAP-3应用: WB,IHC反应种属: Human, Mouse, Rat
-
分类: 科研抗体货号: P12395别名: BBIS; WDR58; fSAP35应用: IHC反应种属: Human, Mouse, Rat
-
分类: 科研抗体货号: P12402别名: CD39; SPG64; ATPDase; NTPDase-1应用: WB,IHC反应种属: Human, Mouse, Rat
-
分类: 科研抗体货号: P12412别名: KMT3C; HSKM-B; ZMYND14应用: WB,IHC反应种属: Human, Mouse, Rat
-
分类: 科研抗体货号: P12394别名: HSPC049应用: IHC反应种属: Human, Mouse, Rat
-
分类: 科研抗体货号: P12401别名: PRKWNK2; NY-CO-43; SDCCAG43; P/OKcl.13应用: WB,IHC反应种属: Human, Mouse
-
分类: 科研抗体货号: P12411别名: PK3; TCB; OIP3; PKM2; CTHBP; THBP1; HEL-S-30应用: WB,IHC反应种属: Human, Mouse, Rat
-
分类: 科研抗体货号: P12393别名: N143; WDR9; C21orf107应用: IHC反应种属: Human, Mouse

鄂公网安备42018502007531号
鄂公网安备42018502007531号

